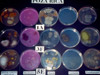
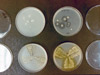

Quem é Biodyne Brasil?
Biodyne Brasil foi fundada em 2016. Nós somos parceiro de negócios exclusiva da Biodyne World, localizada em Sarasota, Flórida, EUA. Biodyne Brasil é uma empresa inovadora trabalhando no uso de microbiologia aplicada como solução para muitos dos problemas comuns do nosso ambiente. A palavra Biodyne significa "poder biológico". O foco do laboratório é aproveitar o "poder biológico" dos microrganismos para uso em processos de biorremediação ambientais.
Biodyne Brasil, como representante exclusiva da Biodyne World, tem instalações, pessoal e conhecimentos necessários para produzir e fornecer produtos, apoio técnicos e microbiológicos utilizados em uma vasta gama de aplicações ambientais.
Sabe-se que o sucesso de inoculações depende em grande parte do suporte. Portanto, a nossa empresa tem um grupo de profissionais qualificados em diferentes áreas da biologia e ambiente preparados para avaliar cada situação para que as aplicações sejam feitas da melhor maneira possível. Da mesma forma, e quando a situação requerer terá suporte do laboratório principal nos Estados Unidos.